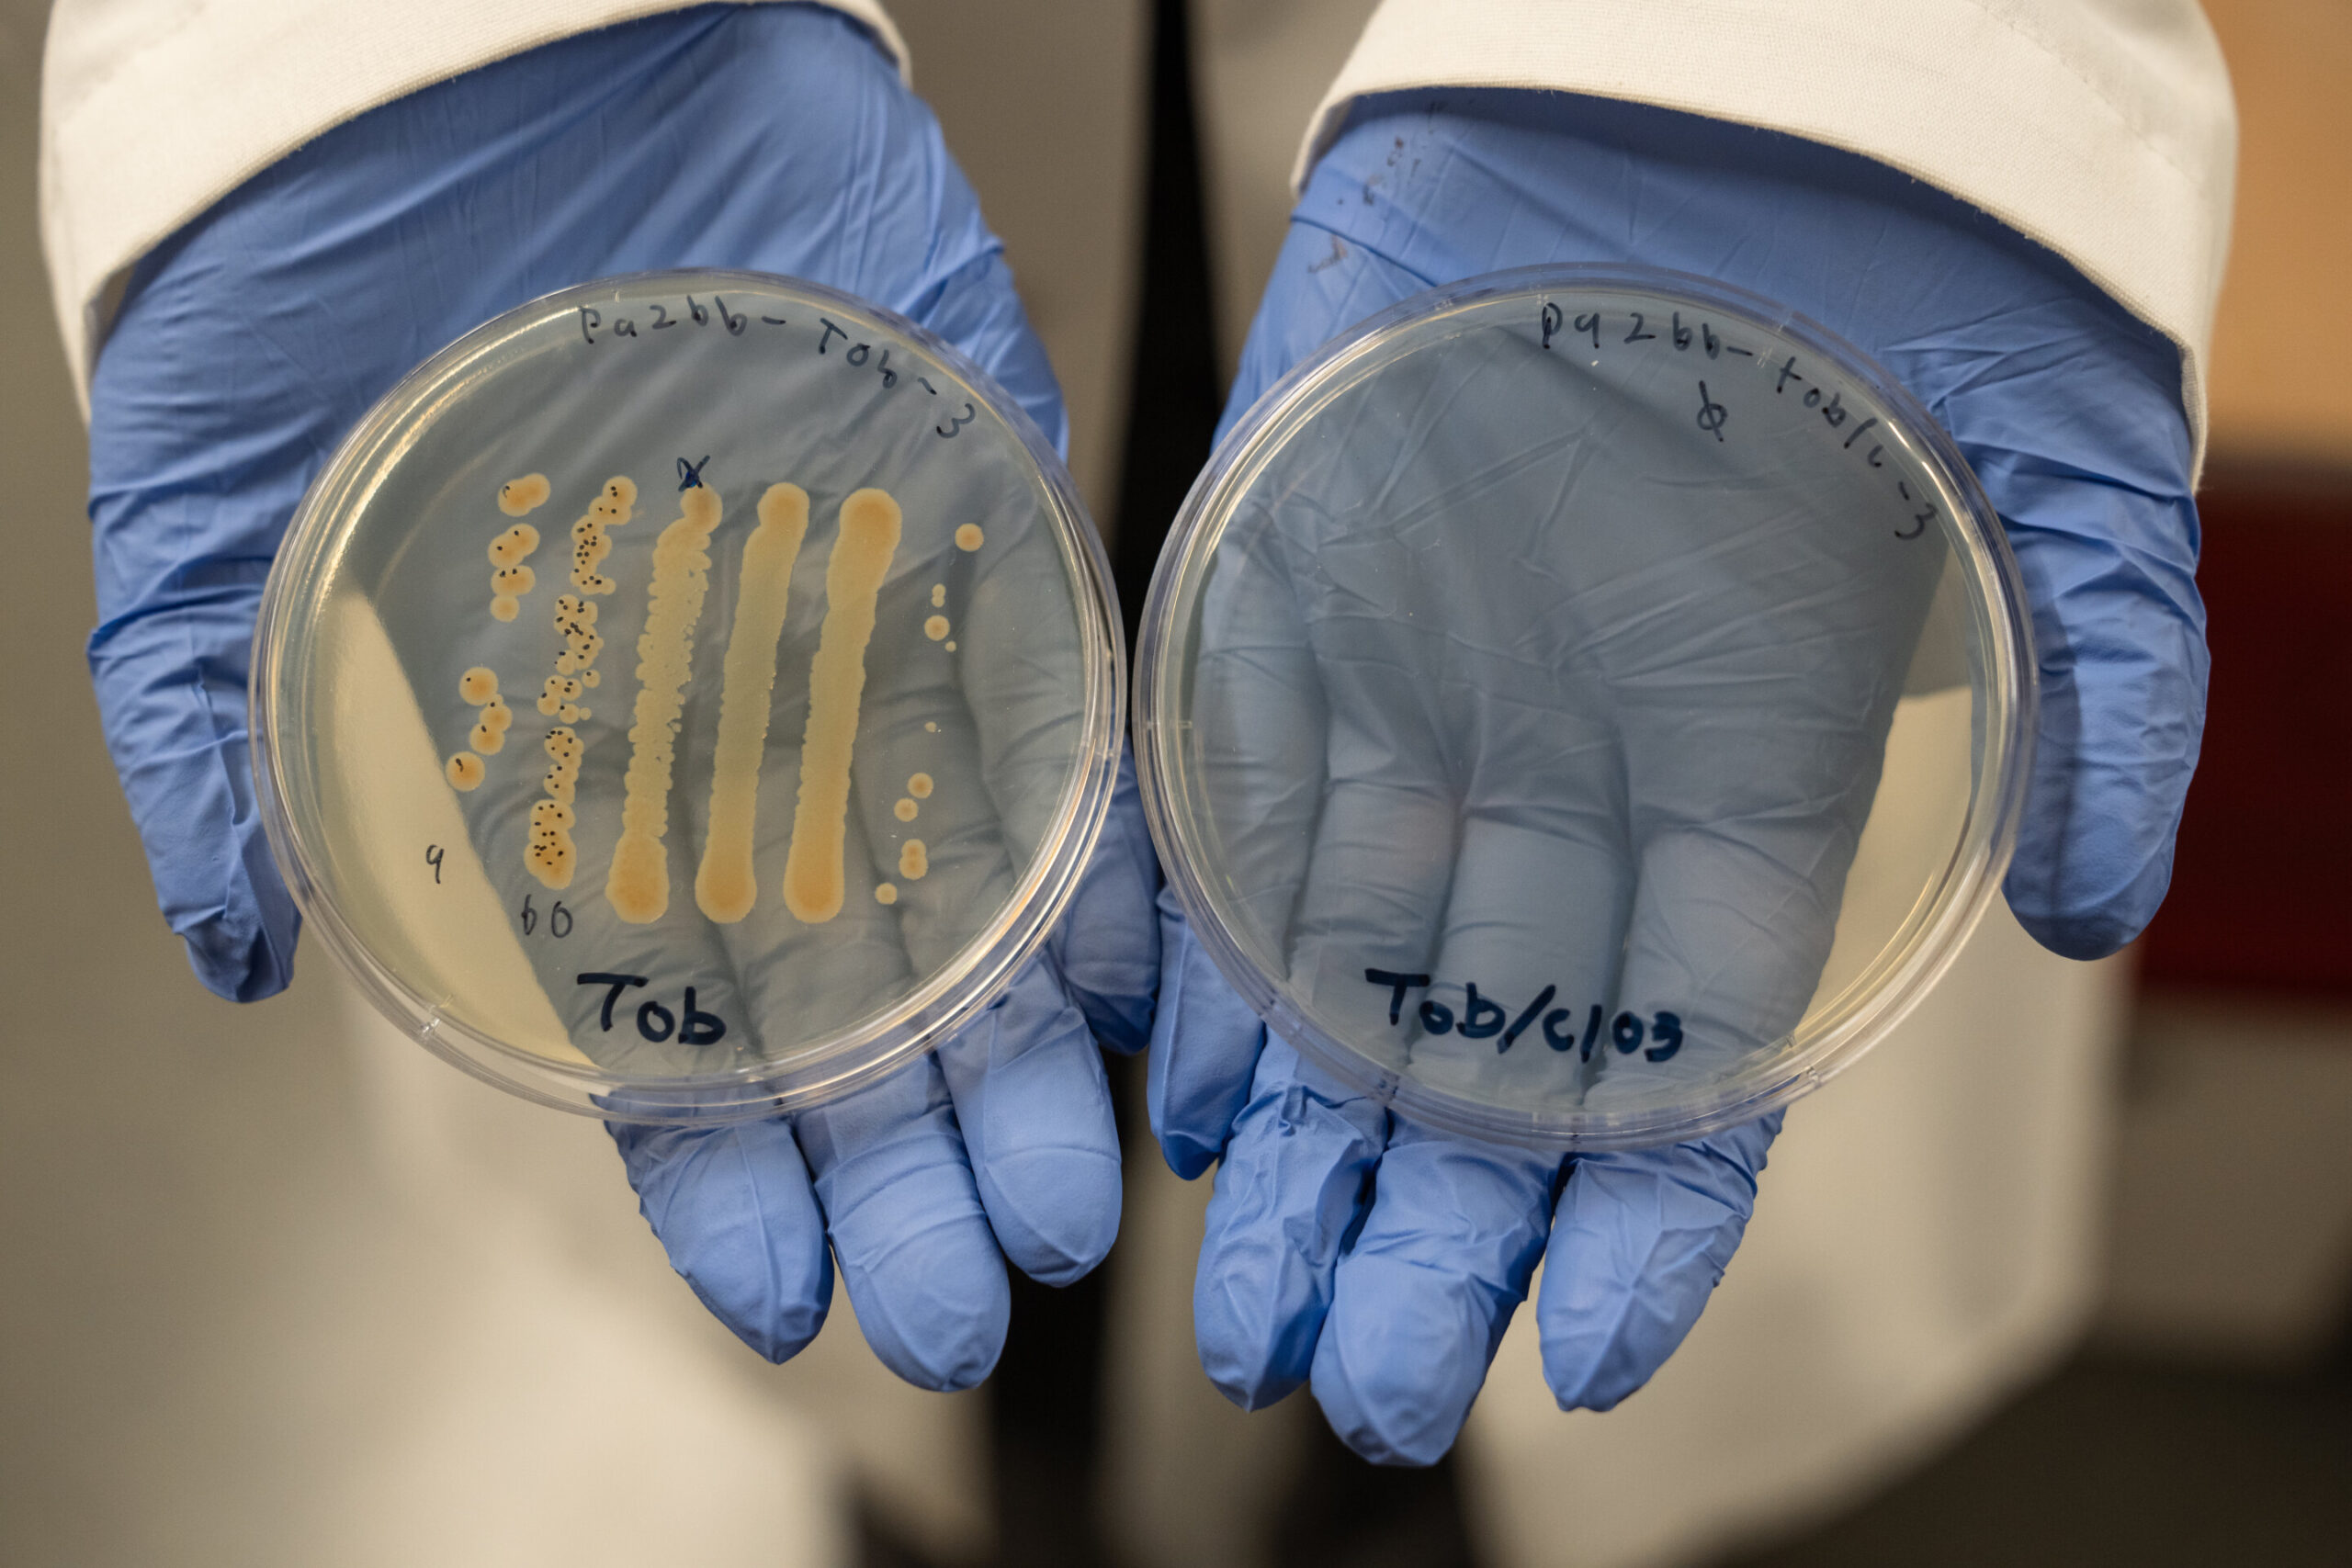
La combinaison à deux médicaments est prometteuse d'aider à guérir les blessures chroniques

Des chercheurs de l’Université de l’Oregon ont testé une nouvelle thérapie médicamenteuse combinée qui pourrait démanteler les bactéries difficiles à traiter habitant les infections chroniques des plaies.
Leurs conclusions, publié. 29 dans le journal Microbiologie appliquée et environnementaleéclairer les moyens de développer des traitements antimicrobiens plus efficaces qui favorisent la guérison dans les plaies chroniques. De tels traitements pourraient également aider à réduire le risque d’infections graves qui entraînent parfois des amputations, telles que les ulcères diabétiques.
L’approche associe des substances connues depuis longtemps qui ne font que peu de temps contre les agents pathogènes difficiles à traiter dans des blessures chroniques, à savoir la bactérie Pseudomonas aeruginosa. Mais en ajoutant de petites doses d’une molécule simple appelée chlorate à des antibiotiques standard, la combinaison s’est avérée 10 000 fois plus efficace pour tuer les cellules bactériennes en laboratoire que les antibiotiques à médicament unique. Ce type de puissance a réduit la dose de médicaments nécessaires pour tuer P. aeruginosa.
Si les résultats peuvent être traduits en humains, ils pourraient aider à raccourcir le temps que les patients doivent être sous des antibiotiques et réduire les risques de toxicité, a déclaré Melanie Spero, professeur adjoint de biologie au Collège des arts et des sciences de l’UO et auteur principal de l’étude.
Bien que étudié ici dans le contexte des infections chroniques des plaies, la stratégie peut être prometteuse pour aborder plus largement la résistance aux antibiotiques.
« Je pense que les combinaisons de médicaments seront une approche critique qui nous aidera à lutter contre la montée de la résistance aux antibiotiques », a déclaré Spero. « Trouver des exemples de synergie parmi les antimicrobiens qui sont déjà sur le marché va être vraiment précieux. Et nous devrons approfondir les mécanismes de la raison pour laquelle ils fonctionnent bien ensemble. »
Défis dans le traitement des infections chroniques des plaies
Une blessure chronique est un tissu blessé qui n’a pas commencé à guérir dans des délais normaux de quatre à 12 semaines. Le type le plus courant est un ulcère de pied diabétique, a déclaré Spero, qui est une plaie ouverte sur le dessous du pied qui se forme à partir d’une mauvaise circulation, une pression prolongée et un manque de sensation.
Selon la recherche publiée par l’American Diabetes Association, environ 1 personne sur 4 atteinte de diabète de type 2 développe un ulcère de pied et plus de la moitié de ces cas sont infectés.
« Une infection active est la complication la plus courante qui empêche la plaie de guérir et de fermer », a déclaré Spero, ajoutant que lorsqu’il est grave, 1 ulcères diabétiques sur 5 nécessite une amputation. « C’est très débilitant, mais il n’y a pas beaucoup de recherches en microbiologie dans ce domaine. C’est donc une opportunité de faire une grande différence. »
Changements dans le flux sanguin, la forte demande d’oxygène des cellules inflammatoires et la présence de bactéries sur le site de la plaie chronique limitent la quantité d’oxygène atteint le tissu, empêchant la guérison. Ces conditions à faible teneur en oxygène sont également le problème même qui rend les infections bactériennes difficiles à combattre: il démasque la résistance et la tolérance aux antibiotiques.
Lorsqu’un site de la plaie devient limité en oxygène, les bactéries passent à la respiration de nitrate pour l’énergie, connue sous le nom de respiration de nitrate. Leur croissance ralentit sans oxygène, mais ils survivent toujours et continuent de se propager.
La croissance lente qui en résulte des bactéries, en particulier P. aeruginosa, les rend notoirement tolérants aux antibiotiques conventionnels. En effet, de nombreux médicaments sont évalués en fonction de la façon dont ils tuent les bactéries à croissance rapide, a déclaré Spero. Mais si les bactéries se développent lentement, ces antibiotiques, qui sont également souvent testés uniquement dans des conditions riches en oxygène, finissent par être inefficaces, a-t-elle déclaré.
Au moins lorsqu’il est administré par eux-mêmes, Spero a trouvé.

Obtenir plus de kilométrage des antibiotiques actuels
Lorsque les antibiotiques sont combinés avec une petite molécule appelée chlorate, il « stressait la cellule bactérienne d’une manière qui la rend super sensible aux antibiotiques », a déclaré Spero.
La recherche s’appuie sur des études que Spero a menées pour la première fois en tant que chercheur postdoctoral au California Institute of Technology. Elle a précédemment constaté que le chlorate, un composé simple qui est inoffensif pour les mammifères et les humains aux faibles doses utilisés dans ses études, transforme les antibiotiques des artistes tièdes en tueurs de bactéries puissants dans les cultures cellulaires et les modèles de souris diabétiques.
Sa dernière étude montre que le chlorate travaille pour rendre toutes sortes d’antibiotiques plus efficaces pour tuer P. aeruginosa et peut réduire la dose d’antibiotique nécessaire pour lutter contre l’agent pathogène. Avec une petite quantité de chlorate dans le mélange, son équipe pourrait utiliser 1% de la dose standard de la Ceftazidime antibiotique à large spectre, a révélé la recherche.
« Dans le cas des infections chroniques, les gens sont souvent sous des antibiotiques pendant de longues périodes, et cela peut faire des ravages sur le corps », a déclaré Spero. « Les médicaments avec des toxicités élevées peuvent perturber les microbes intestinaux et avoir des effets secondaires graves. Tout ce que nous pouvons faire pour raccourcir le temps qu’une personne va être sous des antibiotiques et réduire le dosage, mieux c’est. »
Les résultats proviennent des tests de laboratoire contrôlés sur les cultures de cellules bactériennes, donc la traduction de la clinique est encore loin sur la ligne. D’autant plus que les infections chroniques n’impliquent généralement pas une seule bactérie, a déclaré Spero, car ils hébergent des quartiers microbiens entiers vivant et interagissant ensemble. Donc, découvrir comment les combinaisons de médicaments affectent ces communautés complexes dans les organismes modèles est une prochaine étape évidente, a-t-elle ajouté.
Le mécanisme exact sur la façon dont le chlorate augmente les antibiotiques est également un mystère. Spero a expliqué que le chlorate a été connu par des scientifiques pour détourner la respiration des nitrates, donc en l’absence complète d’oxygène, les microbes sont anéantis. Mais dans les micro-environnements de faibles – ou de haut niveau d’oxygène, les bactéries peuvent en quelque sorte réparer ces dommages et tolérer le produit chimique. Ainsi, dans les projections traditionnelles à un seul médicament, qui sont généralement effectuées dans des conditions à haute teneur en oxygène, le chlorate a été négligé, a déclaré Spero.
« Je pense que c’est ce que nous n’apprécions pas pleinement: les types de contraintes que ces composés imposent à la cellule qui nous sont invisibles », a-t-elle déclaré. « Si notre seule métrique est la viabilité – les bactéries vivent ou meurent? – C’est tout ce que nous rechercherons. Nous devons demander quels processus sont poussés ou stressés dans la cellule qui peuvent entraîner son effondrement en présence d’antibiotiques. »
Spero espère que la recherche de «sous le capot» d’une cellule pendant l’exposition au chlorate-antibiotique montrera aux scientifiques la machinerie biologique de la façon dont les bactéries deviennent sensibles à une gamme d’antibiotiques.
« Cela aura des implications importantes non seulement pour le traitement des infections chroniques des plaies, mais aussi pour le champ de maladies infectieuses et notre lutte contre la résistance aux antibiotiques et l’échec du traitement », a déclaré Spero. « Une fois que nous comprenons les mécanismes de synergie de médicaments, nous pouvons commencer à trouver d’autres molécules qui provoquent ces comportements synergiques, et cela ne ressemblera pas à un jeu de devinettes où nous testons chaque combinaison de médicaments possible. Nous pouvons commencer à faire de la conception rationnelle de médicaments, en utilisant des molécules qui ont déjà été approuvées. »